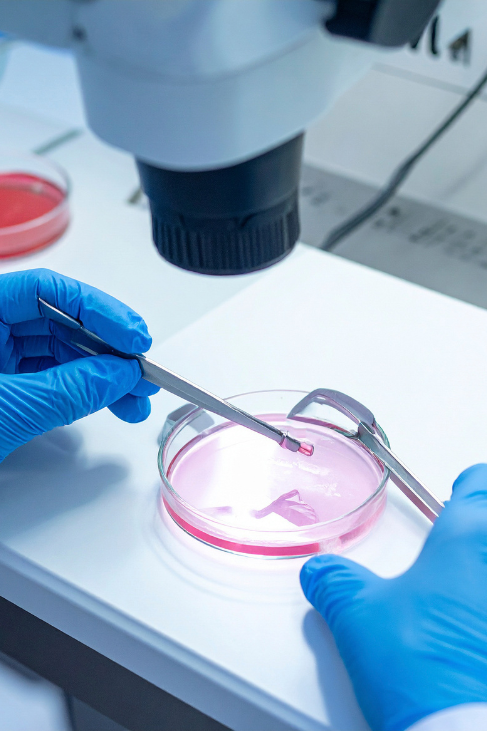
testimonial

How IVF Works at Femcare Fertility
Understanding the process removes much of the fear around IVF. Every cycle at Femcare
Fertility follows a carefully monitored sequence:
-
Baseline assessment: Blood hormone tests, ultrasound scans, semen analysis and a
full review of your medical history. This step identifies the exact cause of difficulty
and rules out conditions that need correction first.
-
Ovarian stimulation: A medication plan tailored to your ovarian reserve, age and
previous treatment responses. Regular monitoring scans track follicle growth and allow
precise dose adjustments.
-
Egg retrieval: Performed under light sedation in a safe clinical setting. The
procedure takes around 20 to 30 minutes and most women return home the same day.
-
Fertilisation and embryo culture: Eggs and sperm are combined in the embryology
lab, by standard IVF or by ICSI depending on your case. Embryos are cultured and graded
for quality over the following days.
-
Embryo transfer: The best embryo is transferred on Day 3 or Day 5 at the
blastocyst stage. The transfer is gentle, takes a few minutes and requires no
anaesthesia.
-
Pregnancy test: Scheduled about 14 days after transfer. Dr. Sayali and her team
remain available throughout this waiting period for questions, reassurance and
monitoring.
IVF Cost in Pune
IVF cost is one of the first questions couples ask and it deserves a clear answer rather than
a vague invitation to enquire. The figures below reflect typical ranges in Pune. Your exact
cost depends on your diagnosis, medication doses and whether additional procedures are
required. Dr. Sayali shares transparent written pricing before treatment begins, so there are
no surprises later.
| Treatment |
Estimated Cost Range in Pune |
Basis |
| First consultation |
Rs. 500 (fixed) |
Femcare Fertility fee |
| IUI (per cycle) |
Rs. 10,000 to Rs. 25,000 |
Industry estimate |
| IVF (one cycle) |
Rs. 1,00,000 to Rs. 2,50,000 |
Industry estimate |
| ICSI (added to IVF) |
Rs. 20,000 to Rs. 50,000 additional |
Industry estimate |
| Frozen embryo transfer |
Rs. 30,000 to Rs. 60,000 |
Industry estimate |
| Fertility preservation (egg freezing cycle) |
Rs. 80,000 to Rs. 1,50,000 |
Industry estimate |
Ranges marked as industry estimates are indicative figures for the Pune region and not a
quotation. Femcare Fertility provides an exact written estimate after your first
consultation.
What Affects IVF Success
Couples often compare clinics on a single advertised success percentage. That number rarely
tells the full story, because success depends on factors that differ from couple to couple:
- Age of the female partner: Egg quality and quantity decline with age, especially
after 35. Earlier consultation preserves more options.
- Underlying diagnosis: PCOS, endometriosis, tubal damage and male factor issues
each respond differently to treatment.
- Embryo quality: Skilled embryology and proper culture conditions directly
influence which embryos reach the blastocyst stage.
- Uterine receptivity: Conditions such as polyps, fibroids or thin endometrium
reduce implantation chances and often need correction before transfer.
- Lifestyle factors: Smoking, alcohol, obesity and unmanaged stress measurably lower
success rates for both partners.
Dr. Sayali discusses realistic expectations with every couple and never quotes inflated
numbers. What she offers is a protocol built on current medical evidence, a fully equipped
embryology setup and consistent follow up care that reduces the avoidable errors which affect
outcomes.
When Should You Consult an IVF Specialist in Pune?
Timing matters more in fertility care than in almost any other branch of medicine. As a
general guideline, couples under 35 should seek specialist advice after 12 months of trying
to conceive without success. Women above 35 should consult after 6 months, because ovarian
reserve declines faster in this age group and waiting reduces options. Couples with a known
condition such as PCOS, endometriosis, irregular cycles, previous pelvic surgery or an
abnormal semen report should not wait at all.
Early consultation does not mean early IVF. In many cases it means simple corrections,
ovulation tracking or a short course of medication that makes natural conception possible.
The real cost of delay is not money. It is the gradual loss of choices that timely diagnosis
would have preserved. If you are unsure whether your situation needs attention, a single Rs.
500 consultation settles the question with facts instead of worry.
What to Expect at Your First Visit
Your first visit is a conversation, not a commitment. Dr. Sayali takes a detailed history
from both partners, reviews any previous reports you bring and performs or schedules the
basic investigations needed for an accurate picture. She then explains what the findings
mean, which options exist and what each option involves in terms of time, cost and
probability.
Couples are encouraged to ask every question on their mind. Nothing is too small or too
awkward. Many patients say the first consultation gave them more clarity than years of
scattered advice from the internet and well meaning relatives.
Serving Patients from Across Pune
Femcare Fertility is located at Suman Business Park in Kalyani Nagar, which makes it easily
reachable from Viman Nagar, Kharadi, Mundhwa, Magarpatta, Koregaon Park, Nagar Road, Yerwada,
Hadapsar and Bund Garden. Many couples from Shivajinagar and Camp also choose the clinic for
Dr. Sayali's reputation for transparent communication and personalised care. Fertility
treatment involves frequent visits during monitoring, so a clinic close to home or work
genuinely reduces the stress of a cycle.
Book Your Consultation
Your first step towards parenthood begins with a conversation. Call
7972996874 or visit Femcare Fertility, Office 102, 1st Floor,
Suman Business Park, Kalyani Nagar, Pune 411014 to book your Rs. 500 consultation with Dr.
Sayali Chavan Shitole.